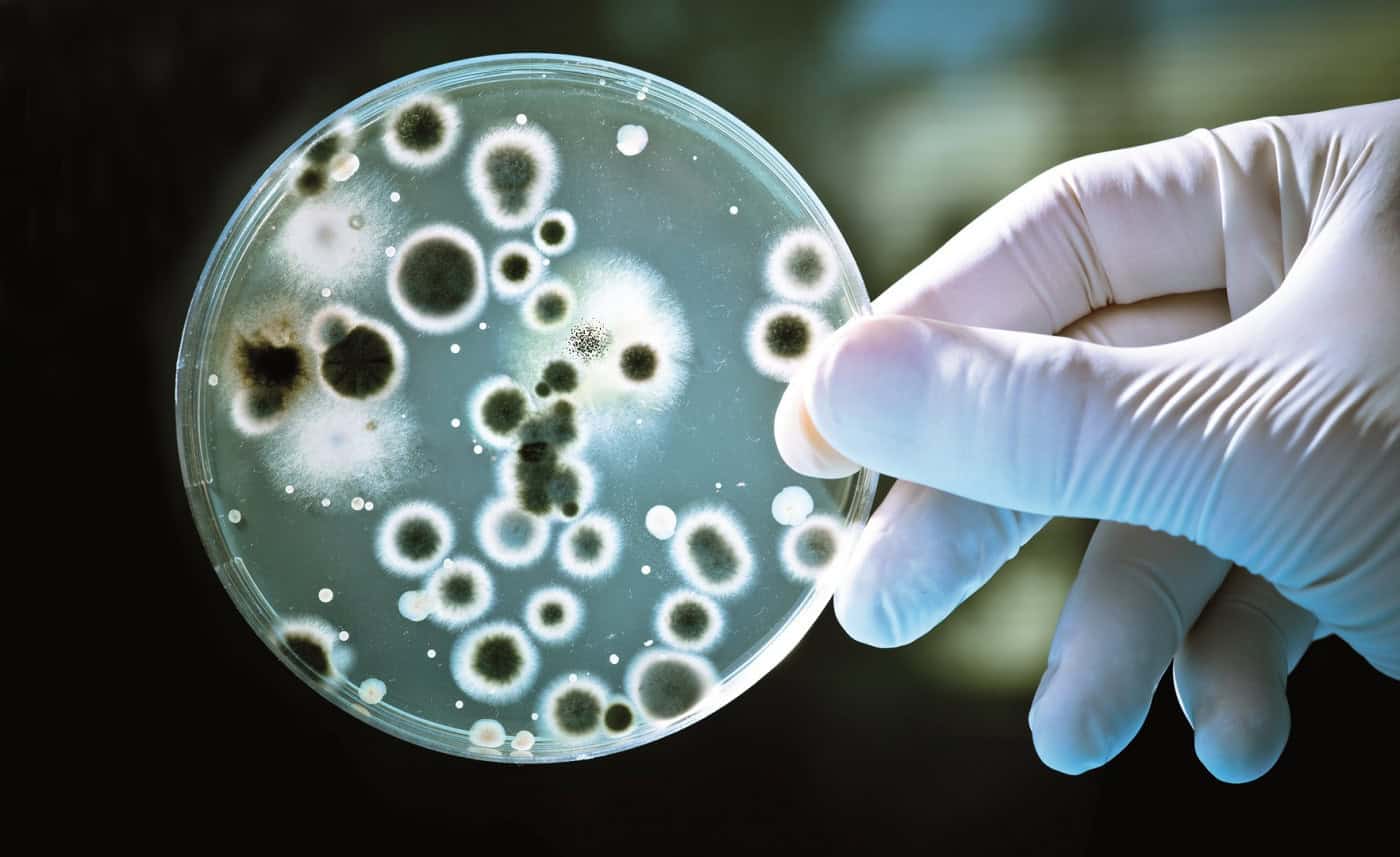
Comunidade mundial de microbiólogos passa uma semana na UMinho

Comunidade mundial de microbiólogos passa uma semana na UMinho
A Universidade do Minho (UMinho) prepara-se para acolher pela primeira vez em Portugal a Conferência Internacional de Coleções de Culturas, já na próxima semana. Trata-se do 15º encontro mundial da estrutura internacional ligada à investigação em Recursos Microbianos.
A iniciativa vai juntar em Braga, de 12 a 16 de junho, 150 participantes de 33 países dos cinco continentes. A organização deste ano está a cargo da Infraestrutura Europeia de Investigação em Recursos Microbianos e a Micoteca da UMinho.
O congresso vai destacar o papel dos micróbios no bem-estar social e na sustentabilidade, como a preservação de alimentos, a produção de vacinas e antibióticos, as bacterioterapias, os biofertilizantes, os biocombustíveis e a valorização de resíduos.
Este congresso internacional decorre de três em três anos e envolve toda a comunidade de microbiólogos e biotencnológica. Acontece pela primeira vez na UMinho, fator destacado pelo responsável do MIRRI, Nelson Lima, já que todos os trabalhos discutidos “têm muito impacto na biotecnologia e na utilização e aplicação dos microorganismos”. Sublinhe-se que a coleção da Micoteca da UMinho é “muito consolidada e respeitada internacionalmente”, além do facto da academia minhota acolher “a única sede europeia de infraestruturas de investigação ligadas aos microorganismos”, o MIRRI.
A preservação e conservação da natureza são regras básicas e no mundo dos microorganismos existem leis específicas que visam esse fim. “Queremos que qualquer país que forneça um mircoorganismo para um desenvolvimento industrial tenha o seu retorno financeiro para a própria preservação da biodiversidade. As indústrias utilizam os microorganismos, têm o seu retorno, mas parte dele tem que ser devolvida ao país de origem”, sublinha.
A abertura oficial está agendada para segunda-feira, às 9h30 no campus de Gualtar com o presidente da Federação Mundial das Coleções de Culturas (WFCC), o presidente da União Internacional das Sociedades de Microbiologia e o representante da Agência Executiva para a Investigação da Comissão Europeia.
Vão também intervir o presidente do Município de Braga, Ricardo Rio e, da parte da organização, o reitor da UMinho, Rui Vieira de Castro, o reitor da Universidade de La Frontera (Chile), Eduardo Hebel, e o coordenador do evento, Nelson Lima, que também dirige a Infraestrutura Europeia de Investigação em Recursos Microbianos (MIRRI-ERIC) e a Micoteca da UMinho. De seguida, são as palestras das conceituadas professoras Ellen Jo Baron, da Universidade de Stanford (EUA), e Rosa Aznar, da Universidade de Valência, entre outros.
